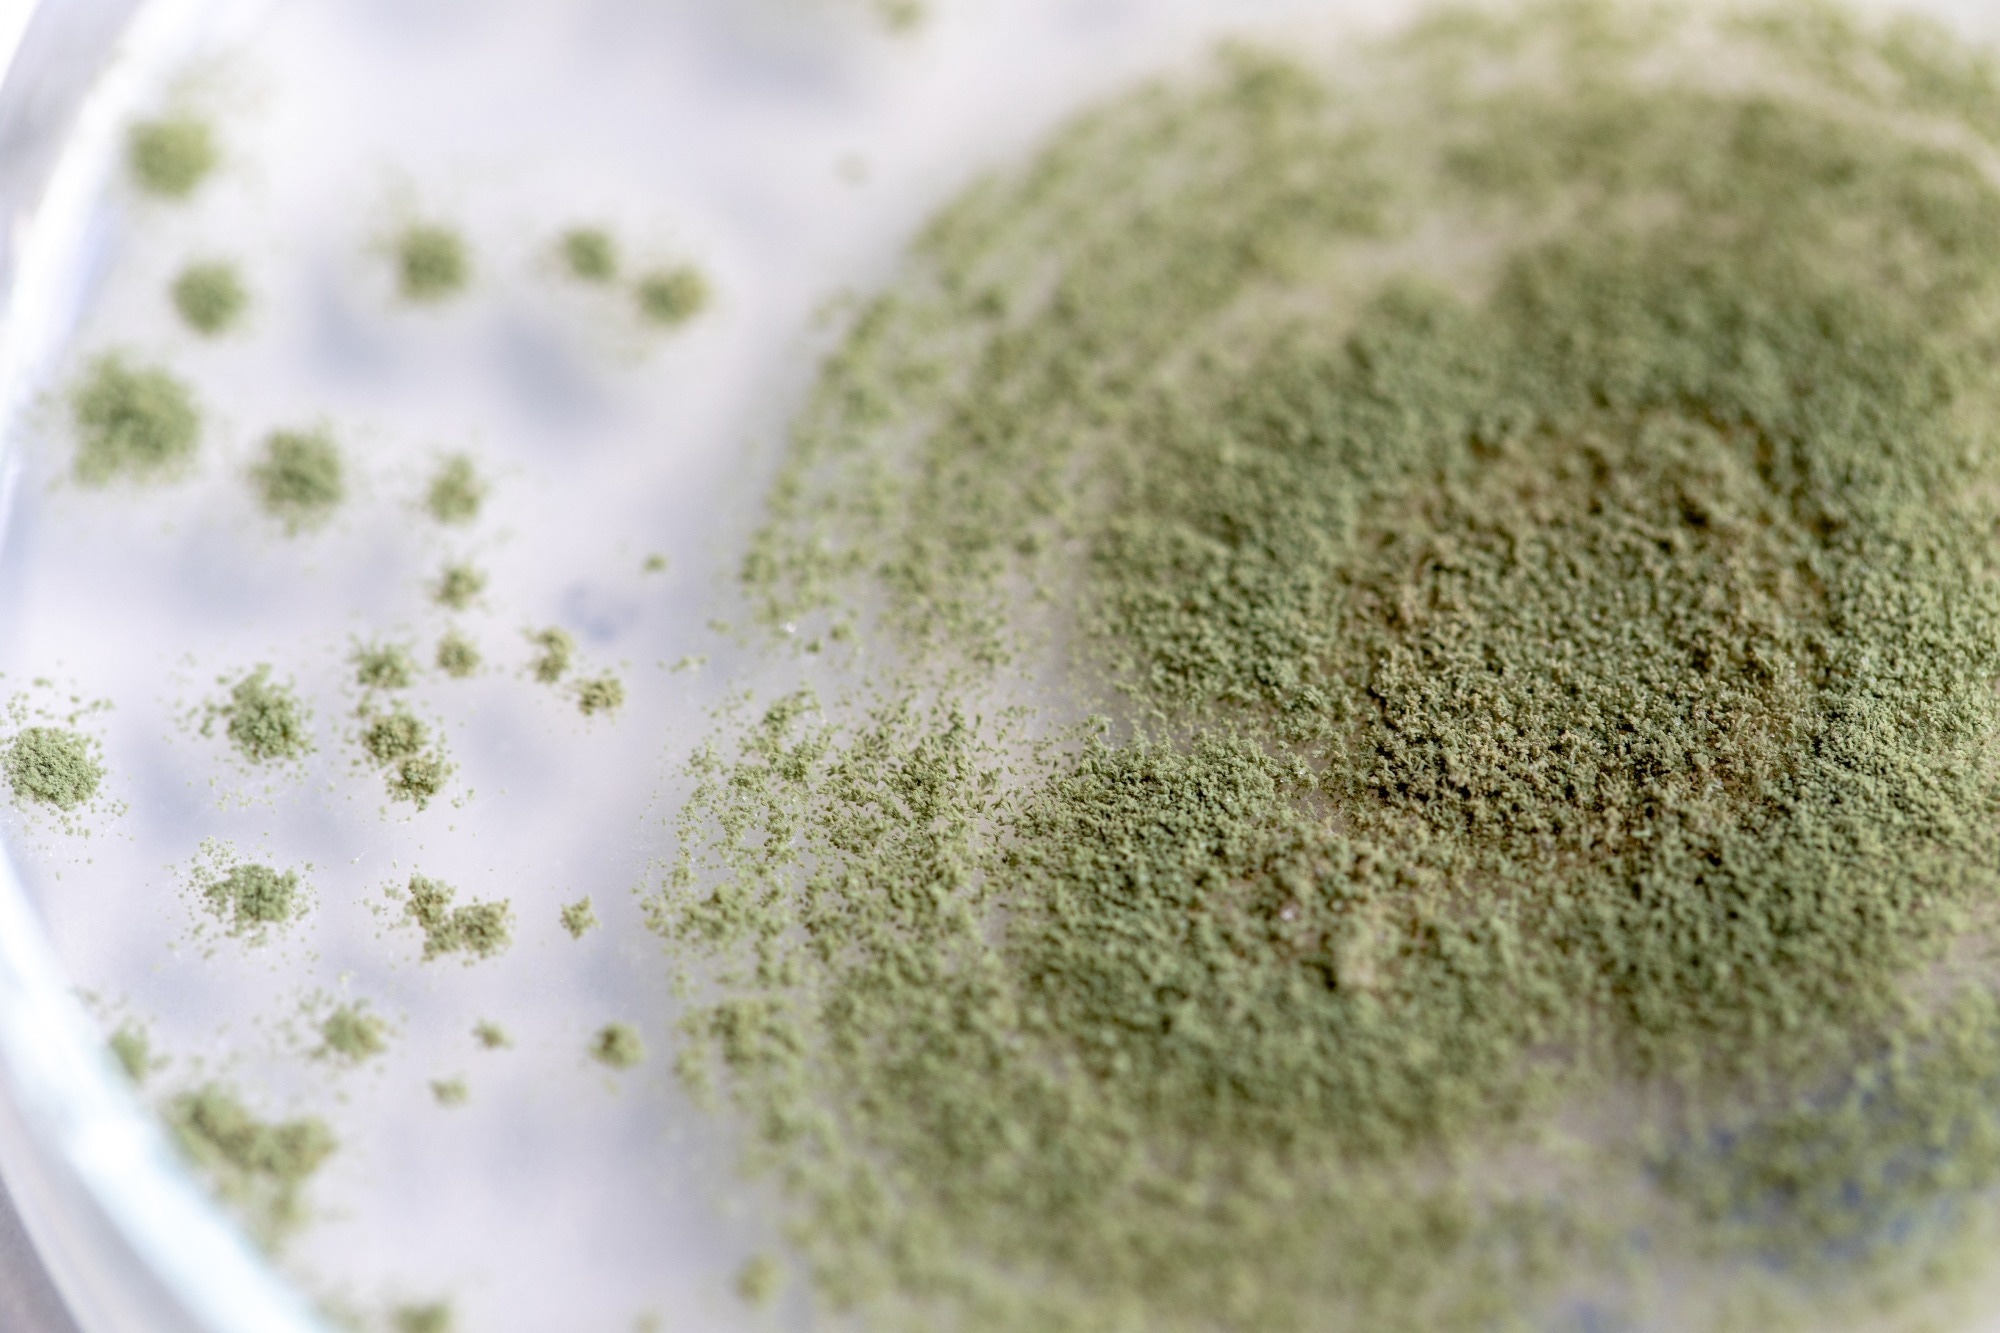

Introduction
Traditional uses of Koji fungus
Biological and enzymatic properties
Koji in functional foods and nutritional science
Emerging scientific findings
Industrial and modern applications
Safety, regulations, and considerations
Future perspectives
References
Further reading
Koji fungus, Aspergillus oryzae, has shaped East Asian cuisine and culture through centuries of fermentation. Today, it is being rediscovered for its nutritional, functional, and industrial potential in modern food science.
Image Credit: Sinhyu Photographer / Shutterstock.com
Image Credit: Sinhyu Photographer / Shutterstock.com
Introduction
Aspergillus oryzae, commonly referred to as the ‘Koji fungus,’ is a filamentous mold that has been used in East Asia for over a millennium. Historical records, such as the Taihōritsuryō legal code (701 A.D.), mention miso, and the Manyōshū (731–733 A.D.) references amazake, highlighting its deep cultural roots. The Koji fungus is considered one of the earliest examples of microbial domestication, achieved through anthropogenic selection of non-pathogenic, enzymatically potent strains.1,3,5
This article discusses the biology of the Koji fungus, its fermentation mechanisms, and its emerging role in modern medicine and nutritional science.

Comprehensive profile of Aspergillus oryzae. The central illustration depicts the morphological structures of A. oryzae, including vesicle, conidia, phialides, conidiophore, and septate hyphae. Surrounding the illustration are key aspects of the fungus, covering its classification, safety profile, description, cultivation requirements, historical use, and genomic characteristics. Created in BioRender. Seidler, Y. (2024) BioRender.com/i28s583.7
Traditional uses of Koji fungus
Unlike most herbs, spices, and other culinary additives, Koji’s primary role in traditional East Asian cuisine is not as an ingredient to be tasted itself, but as a biochemical catalyst that transforms other ingredients.2,5
The term ‘Koji’ refers to a starter culture of A. oryzae. Koji fungus is used to produce miso, shoyu (soy sauce), sake, mirin, amazake, rice vinegar, shochu, and pickled foods.2,5
The starter culture process involves inoculating steamed grains with Koji spores, followed by fungal propagation to create a mycelium-coated grain mass rich in enzymes. The resulting rice, barley, or soybean koji is then introduced to a primary substrate (e.g., cooked soybeans or rice mash), initiating saccharification and fermentation.1,2
Biological and enzymatic properties
The genome of Koji fungus encodes hundreds of enzymes, including proteases, amylases, lipases, and polysaccharide-degrading hydrolases active on cellulose, xylan, and xyloglucan (e.g., GH13 α-amylases, GH31 α-glucosidases, GH43 β-xylosidases) and auxiliary activity AA13 (starch-active) LPMOs. Amylases convert starches into sugars, such as glucose, which fuels yeast in sake production.2,3
Proteases hydrolyze proteins into peptides and amino acids, enriching umami flavors. Secondary metabolites like kojic acid act as antimicrobial agents and natural preservatives.2,3,5
Centuries of domestication differentiated A. oryzae from its close relative A. flavus, which produces aflatoxins. By contrast, A. oryzae is non-toxigenic and designated as GRAS by the U.S. FDA for specified enzyme preparations and uses.6
Koji in functional foods and nutritional science
A. oryzae enhances both flavor and nutrition by increasing bioavailability and generating bioactive compounds. Koji also acts as a source of postbiotic metabolites, modulating gut microbiota and host physiology.1,5,7
Bioactive peptides (BAPs) derived from Koji exhibit antioxidant, antihypertensive, and anti-inflammatory properties. Indigestible components, such as oligosaccharides and glycosylceramides, selectively promote the growth of beneficial bacteria, including Bifidobacterium, which contributes to systemic health.5,7

The potential composition of a postbiotic product derived from Aspergillus oryzae. Postbiotics produced via fermentation with A. oryzae may display a diverse molecular composition. Bioactive compounds in this inanimated fermentation preparations can be organized in four categories: “Non-viable cells or cell-fragments,” “enzymes,” “extracellular polymeric substances,” and “other metabolites”. The latter category is reserved for primary and secondary metabolites not fitting the prior classifications. This categorization provides a structured insight into potential ingredients present in postbiotics derived from A. oryzae.7 Created in BioRender. Seidler, Y. (2024) BioRender.com/f31t998
Emerging scientific findings
Randomized controlled trials (RCTs) show that daily supplementation with Koji-fermented kochujang lowers serum cholesterol in hyperlipidemic patients (34.5 g/day for 12 weeks; −21 mg/dL total cholesterol within-group; trial NCT01865370). A fermented soy product also reduced LDL cholesterol in humans (25 g/day for 12 weeks in a crossover design; total cholesterol decreased by −0.23 mmol/L and LDL by −0.18 mmol/L compared to the control). Animal studies confirm that glycosylceramide impacts liver cholesterol metabolism.5,8,9
Recent work also highlights A. oryzae-derived postbiotics as immunomodulatory agents that may influence host defenses and gut–brain signaling, though human evidence remains limited.7
Despite miso’s sodium content, observational and experimental evidence reviewed to date does not show a clear increase in hypertension risk with habitual miso intake; proposed mechanisms include attenuation of sympathetic nerve activity.10
Industrial and modern applications
Koji has been widely used in biotechnology for a long time. In 1894, Jokichi Takamine commercialized “Taka-diastase,” an A. oryzae enzyme preparation used as a digestive aid. Today, A. oryzae strains are widely applied as “cell factories” for industrial enzymes and specialty metabolites (e.g., kojic acid, organic acids).1,4
Koji-based innovations are spreading into Western gastronomy, where chefs employ it to age meats or enhance vegan charcuterie with umami-rich flavors.2,7
Safety, regulations, and considerations
The GRAS framework affirms safety when approved enzyme preparations from non-toxigenic strains are used in accordance with current good manufacturing practice. The most critical safety concern is preventing contamination by toxigenic Aspergillus relatives.6,7
Modern food strains of A. oryzae are non-pathogenic/non-toxigenic, and industry controls focus on verifying the absence of mycotoxins within regulatory limits; claims of “all mycotoxin pathways deleted” should be avoided unless strain-specific genomic data are provided.4,7
Future perspectives
Future research will likely deconstruct traditional fermented foods to isolate bioactive molecules, then reconstruct them using synthetic biology for the development of functional foods and nutraceuticals. Large-scale, long-term RCTs are essential before clinical recommendations can be made.4
References
- Machida, M., Yamada, O., & Gomi, K. (2008). Genomics of Aspergillus oryzae: Learning from the History of Koji Mold and Exploration of Its Future. DNA Research 15(4); 173-183. DOI:10.1093/dnares/dsn020, https://academic.oup.com/dnaresearch/article/15/4/173/364344.
- The Tokyo Foundation for Policy Research. (2008, December 16). Koji, an Aspergillus. https://www.tokyofoundation.org/research/detail.php?id=243. Accessed on 05 September 2025.
- Matsuzawa, T. (2023). Plant polysaccharide degradation-related enzymes in Aspergillus oryzae. Bioscience, Biotechnology, and Biochemistry 88(3); 276-282. DOI:10.1093/bbb/zbad177, https://academic.oup.com/bbb/article/88/3/276/7464073.
- Sun, Z., Wu, Y., Long, S., Feng, S., et al. (2024). Aspergillus oryzae as a Cell Factory: Research and Applications in Industrial Production. Journal of Fungi 10(4); 248. DOI:10.3390/jof10040248, https://www.mdpi.com/2309-608X/10/4/248.
- Kitagaki, H. (2021). Medical Application of Substances Derived from Non-Pathogenic Fungi Aspergillus oryzae and A. luchuensis-Containing Koji. Journal of Fungi 7(4); 243. DOI:10.3390/jof7040243, https://www.mdpi.com/2309-608X/7/4/243.
- US Food and Drug Administration. (2018, April 1). Enzyme preparations used in food (Partial list). https://www.fda.gov/food/generally-recognized-safe-gras/enzyme-preparations-used-food-partial-list. Accessed on 05 September 2025.
- Seidler, Y., Rimbach, G., Lüersen, K., et al. (2024). The postbiotic potential of Aspergillus oryzae – a narrative review. Frontiers in Microbiology 15. DOI:10.3389/fmicb.2024.1452725, https://www.frontiersin.org/articles/10.3389/fmicb.2024.1452725/full.
- Lim, J., Jung, E., Choi, E., et al. (2015). Supplementation with Aspergillus oryzae-fermented kochujang lowers serum cholesterol in subjects with hyperlipidemia. Clinical Nutrition 34(3); 383-387. DOI:10.1016/j.clnu.2014.05.013, https://www.sciencedirect.com/science/article/abs/pii/S0261561414001587.
- Jung, S. M., Haddad, E. H., Kaur, A., et al. (2021). A Non-Probiotic Fermented Soy Product Reduces Total and LDL Cholesterol: A Randomized Controlled Crossover Trial. Nutrients 13(2); 535. DOI:10.3390/nu13020535, https://www.mdpi.com/2072-6643/13/2/535.
- Ito, K. (2020). Review of the health benefits of habitual consumption of miso soup: focus on the effects on sympathetic nerve activity, blood pressure, and heart rate. Environmental Health and Preventive Medicine 25(1). DOI:10.1186/s12199-020-00883-4, https://ehjournal.biomedcentral.com/articles/10.1186/s12199-020-00883-4.
Further Reading
Last Updated: Sep 16, 2025